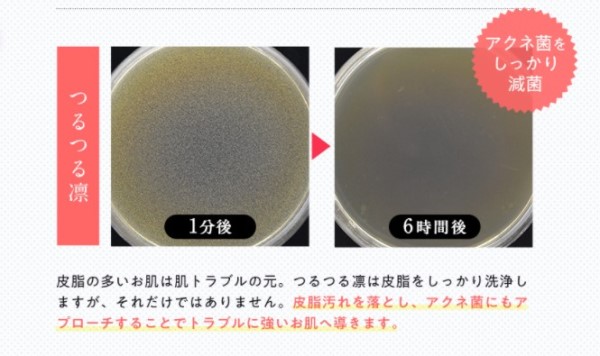

イオン水【つるつる凛】毛穴の黒ずみ、角栓汚れ(原因・症状)除去するには?
お肌トラブルの中でも女性を悩ませる 「毛穴」の問題 は切実です。小鼻や頬など、黒いポツポツと目立つ毛穴の汚れや開きなど気になり出したら止まりません!
悩みの多い毛穴トラブルの原因を理解 して、正しい洗顔方法やスキンケア方法を見直して、つるつるで健康的なお肌を目指しませんか。
毛穴の黒ずみは、すぐ取れることはなくコツコツ続けないと改善できません。
クレンジング・洗顔で洗い残ししがちな皮脂皮脂が空気に触れて酸化すると黒ずみが起きてしまいます。
小鼻と鼻の頭もしっかり洗い、余計な皮脂を取り除けば毛穴の黒ずみケアができます。
ただし洗顔にも注意が必要です。鼻の黒ずみなどの原因はケアのしすぎということもあるからです。無理に取ろうとして擦り過ぎたり、刺激の強い洗顔物を使っていませんか?
そもそも黒ずみは摩擦などの肌へのダメージによって起こるともいわれているのです。
鼻や頬は皮脂腺の活動が活発なので皮脂の分泌が多く、毛穴が目立ちやすいのです。毛穴の悩みは 「毛穴の黒ずみ」 と 「毛穴開き」 の2つがあげられます。少し分かりやすく説明します。
「毛穴の黒ずみ」とは
皮脂の汚れが毛穴に詰まってしまい、角栓の表面が酸化してブツブツと黒くなってしまっている状態を言います。
最初は小さな毛穴詰まりで始まり、さらに毛穴の皮脂や角質(タンパク質)が徐々に溜まることで 角栓(かくせん)ができます。その角栓が酸化して黒くなっているということです。角栓ができてしまうと皮脂が排出されずに毛穴の内部に溜まってしまうのです。
それが原因となり毛穴がポツンと盛り上がっている状態を「面皰(めんぽう)=コメド」といい、皮脂を栄養源としてアクネ菌が増殖するとニキビに進行していきます。
「毛穴開き」とは
皮脂の汚れが溜まってターンオーバー(角質代謝)がうまくいかなくなり、毛穴が引き締まりにくくなって“開き毛穴”の状態になってしまいます。凸凹や開ききってしまった毛穴には、ピーリングなどで肌を柔らかくしながら化粧水や美容液で引き締めるケアがおススメです
[毛穴ケアのすすめ]
フェースケアする際には、お風呂で顔に汗をかいて毛穴を開いた状態でケアされていますか?
ケアは、お風呂に入る前にホットタオルなどで毛穴を開けてからクレイジングや洗顔をするのがオススメです。毛穴のケアしたあとは化粧水・保湿クリームなどでしっかり保湿が大事です。
クレイジングには、油の汚れは油じゃないと取れないので、オイルクレンジングをオススメします。
「黒ずみ」も「開き」も、とにかく毛穴に汚れを詰まらせないようにケアしてしっかり落とすことが最重要になります。
ピーリング効果のある石鹸・ジェルを使って徐々に肌のターンオーバーを促し改善すると思いますか?
ピーリング効果のある石鹸や小鼻のクレイパックなど、適度にスペシャルケアを自宅でも取り入れることもオススメします。
また、洗顔、保湿以外にも、食事、運動、睡眠、ホルモンのアンバランスなどの生活習慣の面、内面のケアは欠かせません。
ニキビのケアをするとともに、発生原因を解消していくことで徐々に肌のターンオーバーが促されて回復してくると思います。オススメは、肌の再生を促す“ビタミンA”や、炎症を抑える効果やコラーゲンを作るのに必要な“ビタミンC”の入った美容液になります。
少し注意すべきところは、酵素洗顔はタンパク質を分解するため毛穴などへの洗浄力は高いのですが同時に同じタンパク質である皮膚も溶かしてしまうことです。
そのため皮膚のバリア機能が失われる事でターンオーバーが乱れて肌トラブルが改善しないという悪循環になったりします。
毛穴の汚れを落としたいと洗浄力の強い洗顔料などを使いたくなりますが、肌に優しい洗顔料に変更して肌のバリア機能を回復させて代謝を促進させる事が最重要かと思います。
毛穴の黒ずみは、アルカリ領域のみでしか落ちないので、アルカリ領域と言えば石鹸がおススメです。
おススメの石鹸は、 自然乾燥製法の枠練り洗顔石鹸 で、洗顔することで徐々に角栓問題が解消する期待がもてます。
毛穴の黒ずみは、キメ細かい弾力のあるクリーミーの泡が作れる自然乾燥製法の枠練洗顔石鹸が一般的です。
[黒ずみ(角栓)の一般的なお手入れ方法]
●鼻の頭や小鼻
鼻の頭や小鼻は特に脂っぽくなりやすい部位です。毛穴が広がり皮脂や汚れなどがつまりやすくなります。
正しいクレンジングと洗顔を行って、毎日清潔に保つことを心がけましょう。
●顔全体
顔全体の中でも、鼻だけでなく、額も皮脂量が多く、毛穴に皮脂がつまりやすい部位です。洗顔の際はていねいに優しく洗し余分な脂肪分を取り去ることが必要です。
しかし皮脂を落とす力が強すぎるものや、使い過ぎは肌を傷める恐れがあり、脱脂状態をまねいて肌乾燥にもつながってしまいます。乾燥しがちな部位には、適切な保湿を心がけましょう。
●食習慣
皮脂の分泌を抑えるために、脂質代謝に必要となる ビタミンB2 や皮脂の酸化を防ぐ ビタミンE などを積極的に摂取しましょう。
■ビタミンB2 を多く含む食品
ビタミンB2は皮膚や粘膜の機能を正常に保つことに関係しています。
魚介類(魚肉ソーセージ)、肉類(レバー)、藻類(焼きのり)、豆類(納豆)、乳類(チーズ)、卵類、野菜類(しそ)、種実類(アーモンド)など
■ビタミンE を多く含む食品
ナッツ類(アーモンド)、胚芽油、ウナギなどの魚介類、大豆、穀類、緑黄色野菜など
●生活習慣
過度なストレスや運動不足はホルモンバランスが崩れて毛穴が目立ちやすくなると言われています。
適度な運動やストレス発散、食生活などの生活習慣を改善すれば黒ずみができにくくなり、心身も健康に保てます。
肌環境に合った生活習慣と常に肌を清潔維持することが大切なことは間違いないことです。
肌スキンケアのみに気を付けていても、小さいことですがフェースタオルにも清潔にしておくことやストレスに伴って喫煙が増えないように減らす努力や禁煙に向けての意思を強く持つことも大切だということです。
タバコ は血管が収縮し肌に必要な酸素や栄養素が行きわたりずらくなるばかりか美肌に欠かせないビタミンCを大量に消費し肌の新陳代謝を低下させてしまいます。
タバコは心身のストレスの解消のために吸うのか、肌トラブルを解消するために減らすのかバランスを意識して気をつけていただきたいと思います。
毛穴の黒ずみは、皮脂や汗、落ちきれなかった化粧カスやホコリなどが毛穴に詰まっていることが原因です。毛穴汚れは頑固なので、本当に落とすのが難しいと言われています。
[毛穴黒ずみ対策「つるつる凛」]
ここで一つご紹介したいケアアイテムがあります。
高機能還元イオン水「つるつる凛」 です。毛穴に詰まった汚れがゴッソリ取れるミストだと話題になっているケアアイテムです
従来の毛穴ケアでは、刺激が強く毛穴が広がることもありましたが、つるつる凛を使用すると肌を擦らず優しくしっかりと洗浄できます。詳しくはこれからご紹介したいと思います。
イオン水【つるつる凛】毛穴の黒ずみ、角栓汚れケア対策
「つるつる凛」 は、毛穴の黒ずみ除去に特化したミストです。汚れた毛穴をきれいにして、開いて閉まった毛穴をキュっと引き締める効果があります。
従来の毛穴ケアでは、刺激が強く毛穴が広がることもありましたが、つるつる凛を使用すると肌を擦らず優しくしっかりと洗浄できます。
[つるつる凛の肌に優しいイオン水の特徴]
高機能還元性イオン水は化粧水などにも使われるほど肌に優しいイオン水です。
成分はアルカリ性ですが、肌に触れると弱酸性に変化するため肌への刺激が少ないのが特徴で、敏感肌の方でもお使いいただけます。
また水に比べて表面張力が低いため、細かい隙間にも浸透しやすく、皮脂汚れや油汚れなども落としやすいことから様々な美容用品や掃除用具にも使われております。
[毛穴の黒ずみ、角栓汚れケアの効果]
●毛穴汚れを溶かす
世界が認めた特許製法で作られた高機能還元イオン水が、毛穴汚れを溶かして黒ずみを除去してくれます。
クレンジングや普段の洗顔で落とせなかった毛穴汚れを、磁石と同じような反発力で引きはがします。
敏感肌でも安心・安全の自然素材100%で作られていて、さらに無添加です。その他にも、アクネ菌を殺菌する効果や保湿効果も期待できるので、毛穴の黒ずみを落としながら保湿も同時にしてくれる優れものです。
●皮脂や汚れをしっかり取り除く
つるつる凛は特許を取得した 高機能還元イオン水 で、非常に高い浸透力と洗浄力があります。
そのため、マイナスイオンの反発力によって毛穴の汚れを引き離すことができるのです。
一般的なクレンジングや洗顔では落としきれないほどの、皮脂や角栓などの汚れをしっかり取り除く作用が期待できます。
つるつる凛の配合成分はとてもシンプルで、ベースは高機能還元イオン水のみです。
また、大気汚染や花粉など外部刺激から肌を守るアンチポリューション効果があり、肌を整えるのにも効果的です。
●背中ニキビ・VIOの色素沈着に効果
つるつる凛には、背中ニキビやVIOの色素沈着などに対して特別な効果が期待できる成分は含まれていません。
ただ、ニキビの炎症を抑える効果は期待できないものの、アクネ菌の殺菌効果はある程度期待できます。
背中の炎症性ニキビが気になる場合は、抗炎症成分が入ったニキビの治療薬との併用がおすすめです。
防腐剤無添加で敏感肌でも安心して使えるものの、特別色素沈着に効果的とされる美白効果などは見込めないので注意してください。
[高機能還元イオン水「つるつる凛」簡単ケア]
高機能還元イオン水「つるつる凛」 は、花粉など日常生活で起きる肌荒れや、毛穴汚れに特化した美容アイテムといえます。
高い浸透力と洗浄力をもつ「つるつる凛」が清潔な毛穴・肌を整え保持してくれます。人によりますがお肌に合わせた現在使われているスキンケアを塗布して潤いある保湿された整った肌を目指してください。
[補足肌ケア①] 肌乾燥を防ぎ、保湿ケアをしっかり行う
大人のニキビは角質層のターンオーバーに原因があることが分かっています。肌の乾燥もターンオーバーを低下させるため、洗顔後などはたっぷりと水分補給をするなど、保湿を心がけましょう。
[補足肌ケア②] 日常生活を改善する
規則正しい生活をして十分な睡眠をとり夜更かしをしない、暴飲暴食をしない、脂肪の多い食事や甘いものなどは避けるなどしましょう。
「つるつる凛」は、朝晩の1日2回、洗顔後に顔全体にスプレーで吹きかけて30秒待ってから、拭き取るか水で軽く洗い流すだけの簡単ケアです。ゴシゴシと洗うことなく肌にとても優しいアイテムです。
毎日朝晩継続して使うことで徐々に毛穴の黒ずみを薄くしながら除去していきます。
そのため、1回の使用や1週間などの短期間の使用状況では効果が実感しにくく、まずは、1か月以上使い続けてみることをおすすめします。
イオン水【つるつる凛】肌予防・洗浄・保湿力の効果と格安情報
「つるつる凛」 は、洗顔後に顔全体にスプレーで吹きかけて30秒待ってから、ティッシュなどで拭き取るか軽く水洗いする程度で完了するお手軽簡単ケアアイテムです。
[イオン水【つるつる凛】肌予防・洗浄・保湿力]
高機能還元イオン水 は、表面張力が水よりも低いので肌への浸透力が強く、毛穴の奥まで有効成分が届くので、頑固で落としにくい毛穴の黒ずみをスッキリ除去します。
「つるつる凜」は、高機能還元イオン水で毛穴の汚れを落とし保湿力もありますが、保湿に特化しているコスメではないので、年々乾燥肌に悩まれている方で保湿に物足りなさを感じられたら保湿美容液や保湿クリームを併用してください。
毛穴の汚れが簡単に落ちるのに刺激がほぼ無く、肌に優しいイオン水で、使ったあとは逆にモチモチする感じがします。
つるつる凛は自然由来の成分で肌にもよさそうです。使用したあとは さっぱりツルツル なのに乾燥しません。使い続けていると、 毛穴もキュッ と閉まってきた感じがあると言われています。
なによりも、肌をこすって負担をかけることなく汚れも落ちる新感覚のスプレー式の毛穴ケアアイテムなのがポイントです。
顔全体に吹きかけ30秒待って洗い流すだけで洗顔代わりになり、忙しい朝の支度などでバタバタしてるなかで、ぱぱっと毛穴ケアできちゃうのは時短になり、とてもありがたいと思います。
[「つるつる凛」の使い方]
●朝の使い方
1、洗顔の代わりに「つるつる凛」を顔全体に8~10プッシュして吹きかける
2、30秒待つ
3、ティッシュで拭き取るか軽く水洗いで流す
●夜の使い方
1、クレンジングでメイクなどの汚れを落とす
2、W洗顔の代わりに「つるつる凛」を顔全体に8~10プッシュして吹きかける
3、30秒待つ
4、ティッシュで拭き取るか軽く水洗いで流す
朝使うことで、睡眠中に分泌された皮脂や汗、ホコリなどの汚れ付着を取り除きます。夜は1日の毛穴汚れをスッキリ落とすので、毎日朝晩の2回使用することで、毛穴に汚れが溜まる心配がありません。
[「つるつる凛」お得な格安情報]
つるつる凛は公式サイトのみでの販売となっています。
楽天やAmazonなどの通販サイトや薬局などでは販売されていません。
公式サイトでは、①「お肌つるりん定期コース」②「全身つるりん定期コース」の2つの徳定期コースが用意されています。
①「お肌つるりん定期コース」(初回1本で通常価格7,700円(税込))
・初回限定価格 4,378円(税込)
2回目以降も 1本あたり4,378円(税込)×2本で 8,756円(税込)(送料無料)
・2回目は1か月後に2本、3回目以降は2か月おきに2本お届けするコース
・30日間全額返金保証付き
②「全身つるりん定期コース」(3本の通常価格23,100円(税込))
・初回限定価格 10,978円(税込)
2回目以降 12,100円(税込)
・3か月毎に3本お届けするコース
・90日間全額返金保証付き
上記の定期コースは、どちらも1回目の購入後に中止や休止が可能です。
単発購入はできませんが、肌に合わない、あるいは効果を感じられないといった場合にいつでも解約ができます。
気軽にお試しができ、顔全体に吹きかけて30秒待ってから洗い流すだけの簡単ケアなので、忙しい方でも継続しやすい商品だと思います。
このページでは、インターネット通販で人気の高いアイテムについての情報を掲載しています。たくさんあるアイテムの中で、低価格、安値、最安値、激安などコスパ面でお得感があり、どんなお悩み、こだわり、好みに対して解決できる具体的な、特徴、効能、成果、結果、使用感、メリット、デメリットなどを分かりやすく説明。公式サイト、ブログ、関連サイト等の優良情報から、クチコミ、口コミ評価、レビュー、Q&A、使い方、使用方法、選び方、やり方、注意事項などを調べて、感想、評価、評判などをまとめ、おススメポイントやより効果が期待できる最適な方法などをまとめています。その他、豪華特典、返金保証、保証、即納、割引、割引ポイント、解約方法、送料無料などの更なるお得情報をご紹介。期間限定、特別キャンペーン、お試し、トライアルキット、トライアルセットなどの限定情報やYouTube、アットコスメ、NAVER、CM、雑誌などの情報も調べ掲載していきます。